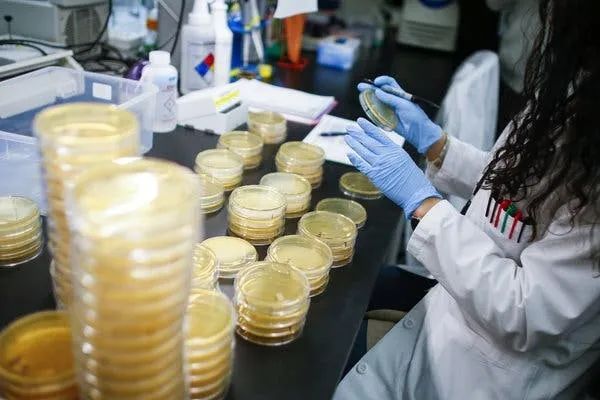
斯坦福大学推出新冠病毒检测试剂盒，可快速出结果

斯坦福大学推出新冠病毒检测试剂盒,可快速出结果
编者按:本文来自微信公众号“PingWest品玩”(ID:wepingwest),作者邢逸帆,36氪经授权发布。
美国疑似患者的确诊时间从 72 小时缩短至 12-24 小时。
斯坦福大学的研究人员已经开始启用自己开发的新冠病毒检测试剂盒。
3月5日,斯坦福大学医学中心发文称,斯坦福大学临床病毒学实验室从 1 月下旬开始开发试剂盒,如今试剂盒的准确性已经通过验证并开始在斯坦福医疗中心(Stanford Health Care)和斯坦福儿童医疗中心(Stanford Children's Health)投入使用。
负责开发试剂盒的斯坦福临床病毒学家本杰明·平斯基(Benjamin Pinsky)博士表示,新试剂盒可以“成功检测出新冠病毒,而不会与其他类型的冠状病毒或流感病毒发生交叉反应”。
 新试剂盒投入使用后,可以在 12-24 小时内完成采集样本到出测试结果的全过程,而此前美国疾病控制与预防中心(CDC)的测试则需要近 72 小时的流转时间。
新试剂盒投入使用后,可以在 12-24 小时内完成采集样本到出测试结果的全过程,而此前美国疾病控制与预防中心(CDC)的测试则需要近 72 小时的流转时间。截至本周五,新冠病毒已在美国造成 290 例感染和 15 例死亡,对于新冠肺炎疫情快速扩大的美国来说,尽快确诊疑似患者并阻止进一步传播是目前的当务之急。然而直到本周为止,CDC 仍是全美国唯一能进行病毒样本检测的机构。
 ▲CDC 目前使用的病毒检测试剂盒
▲CDC 目前使用的病毒检测试剂盒在不断增长的疫情压力下,美国终于开始将病毒检测权限下放。
2月29日,美国食品药品监督管理局(FDA)推出新政策,放宽了美国实验室进行病毒检测的条件,允许实验室在获得“紧急授权”之前快速启用自己开发的试剂盒。
“诊断能力是美国迅速排查新冠病毒、控制疫情发展的关键……新政策是为了尽可能地加快诊断速度。” FDA 解释道。
在闸门放开后,美国各地的实验室迅速开始分担检测压力。据美国公共卫生实验室协会称(APHL),本周二已经有 54 个地方和州实验室开放了病毒测试,除斯坦福大学之外,加利福尼亚大学旧金山分校也即将开始启用自己开发的试剂盒。
▲研究人员正在开发新冠病毒检测试剂盒,图源:Kena Betancur
▲研究人员正在开发新冠病毒检测试剂盒,图源:Kena Betancur与目前中国普遍使用的试剂盒相同,斯坦福开发的试剂盒也采用了聚合酶链式反应法(RT-PCR)。
在患者鼻腔或口腔刮擦样本后,样本将被导入试剂中。试剂中含有一小段“引物”DNA,一旦发现新冠病毒就会牢牢地吸附在上面,并转录成为一条与病毒 RNA 互补的 DNA 链条,就像是新冠病毒的“倒影”一样。
 ▲用于刮擦鼻腔的拭子接着,DNA 将在聚合酶的作用下生成数十亿个 DNA 拷贝,哪怕只有一个新冠病毒混入其中,也会产生明显的“倒影”。
▲用于刮擦鼻腔的拭子接着,DNA 将在聚合酶的作用下生成数十亿个 DNA 拷贝,哪怕只有一个新冠病毒混入其中,也会产生明显的“倒影”。 ▲在这台机器中,新冠病毒的转录 DNA 正在疯狂拷贝
▲在这台机器中,新冠病毒的转录 DNA 正在疯狂拷贝为了防止混淆新冠病毒和其他相似病毒,在选取“引物”时要选取新冠病毒独具特色的靶基因。在进行测试时,斯坦福大学选择首先筛查编码被膜蛋白的病毒 RNA。这种蛋白存在于新冠病毒的外膜中,并在病毒的生命周期中起着重要作用,包括从受感染宿主细胞中萌芽。发现被膜蛋白基因后,斯坦福测试会追加一段 RNA 复制酶检测来得出阳性结果。
然而斯坦福测试和其他已有的冠状病毒测试一样,尚未明确在患者在出现症状之前是否能检测出病毒,以及患者在感染多久之后才能被测出病毒,无法完全避免假阴性的测试结果。
但 FDA 释放地方实验室潜力的举措,以及斯坦福等高校的参与至少解决了样本流转时间过长的问题。由于新冠病毒样本变异速度快,留存时间短,如果在运送过程中耽误太久,很可能让本来就没多少的病毒在路上就消失殆尽,就算送到实验室也测不出来了。把 CDC 从检测样本的流程中摘出去,会大大提高美国对新冠病毒样本检测的准确度和效率。相关推荐
斯坦福大学推出新冠病毒检测试剂盒,可快速出结果
做到22分钟出结果,「天深医疗」研发新冠病毒新型试剂盒
加拿大新冠肺炎快速检测盒被发现检测结果不可靠
168元一个,审批中的新冠病毒检测试剂盒被微商叫卖
帮助追踪新冠感染源,「路胜生物」发布全球首个新冠病毒亚基因组RNA检测试剂盒
出海潮连着退货潮,国产试剂盒的一波三折
新冠病毒试剂盒背后:中国科技与发达国家的差距有多大?
谷歌一名员工新冠病毒检测结果呈阳性
检测新冠病毒,AI功能终于找到真正价值?
国产试剂盒的一波三折
网址: 斯坦福大学推出新冠病毒检测试剂盒,可快速出结果 http://www.xishuta.cn/zhidaoview7402.html
推荐专业知识

- 136氪首发 | 瞄准企业“流 3930
- 2失联37天的私募大佬现身,但 3220
- 3是时候看到全球新商业版图了! 2809
- 436氪首发 | 「微脉」获1 2759
- 5流浪地球是大刘在电力系统上班 2708
- 6招商知识:商业市场前期调研及 2698
- 7Grab真开始做财富管理了 2610
- 8中国离硬科幻电影时代还有多远 2328
- 9创投周报 Vol.24 | 2186
- 10微医集团近日完成新一轮股权质 2181










